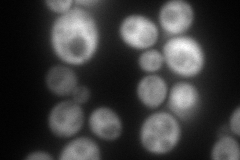
YLL026W
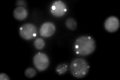
YLL026W
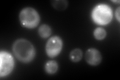
YLL026W

View description
Heat shock protein that cooperates with Ydj1p (Hsp40) and Ssa1p (Hsp70) to refold and reactivate previously denatured, aggregated proteins; responsive to stresses including: heat, ethanol, and sodium arsenite; involved in [PSI+] propagation
Localization:
Intensity:
Fold change:
Significance:
-
C’ GFP library in SD

cytosol340.17 -
N' NOP1pr-GFP in SD

cytosol213.889 -
N' TEF2pr-mCherry in SD
cytosol213.512 -
N' NATIVEpr-GFP in SD

nucleus163.024 -
N' TEF2pr-VC and Cyto-VN in SD

cytosol49.6513 -
C’ GFP library in SD+DTT

cytosol827.52.43Yes -
C’ GFP library in SD+H2O2

cytosol606.51.78Yes -
C’ GFP library in Starvation Media
punctateN/AN/AYes -
C’ GFP library on the background of Pup2-DaMP
punctate -
C’ GFP library on the background of CCT mutant

punctate369.1941.08529No
